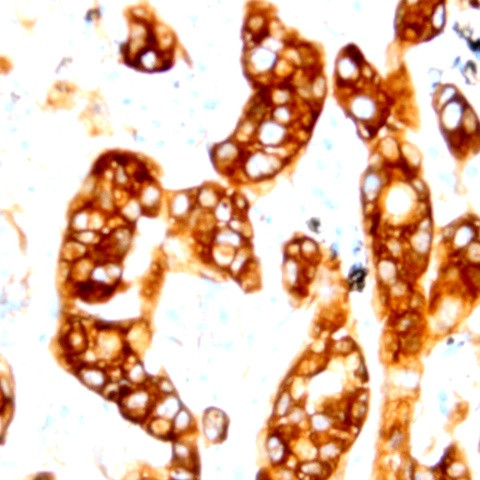
Neuropilin-2 Antibody in Immunohistochemistry (Paraffin) (IHC (P))

Search
AbboMax
Neuropilin-2 Polyclonal Antibody
{{$productOrderCtrl.translations['antibody.pdp.commerceCard.promotion.promotions']}}
{{$productOrderCtrl.translations['antibody.pdp.commerceCard.promotion.viewpromo']}}
{{$productOrderCtrl.translations['antibody.pdp.commerceCard.promotion.promocode']}}: {{promo.promoCode}} {{promo.promoTitle}} {{promo.promoDescription}}. {{$productOrderCtrl.translations['antibody.pdp.commerceCard.promotion.learnmore']}}
图: 1 / 2
Neuropilin-2 Antibody (630-600) in IHC (P)


产品信息
630-600
种属反应
宿主/亚型
分类
类型
抗原
偶联物
形式
浓度
纯化类型
保存液
内含物
保存条件
运输条件
产品详细信息
Positive control: Kidney tissue
Cellular location: Secreted and membrane.
靶标信息
This gene encodes a member of the neuropilin family of receptor proteins. The encoded transmembrane protein binds to SEMA3C protein (sema domain, immunoglobulin domain (Ig), short basic domain, secreted, (semaphorin) 3C) and SEMA3F protein (sema domain, immunoglobulin domain (Ig), short basic domain, secreted, (semaphorin) 3F), and interacts with vascular endothelial growth factor (VEGF). This protein may play a role in cardiovascular development, axon guidance, and tumorigenesis. Multiple transcript variants encoding distinct isoforms have been identified for this gene.
仅用于科研。不用于诊断过程。未经明确授权不得转售。
篇参考文献 (0)
生物信息学
蛋白别名: Neuropilin-2; neuropilin-2a(17); neuropilin-2a(22); neuropilin-2b(0); receptor for VEGF165 and semaphorins class3; Vascular endothelial cell growth factor 165 receptor 2
基因别名: 1110048P06Rik; Np-2; NP2; Npn-2; NPN2; NRP2; PRO2714; VEGF165R2
UniProt ID: (Human) O60462, (Mouse) O35375, (Rat) O35276
Entrez Gene ID: (Human) 8828, (Mouse) 18187, (Rat) 81527